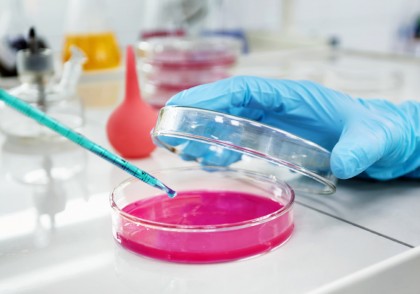
Zincul eliberat din sticla de laborator, o cauză ascunsă a eșecurilor în fertilizarea in vitro

Zincul eliberat din sticla de laborator, o cauză ascunsă a eșecurilor în fertilizarea in vitro
Un studiu publicat în aprilie 2025 în revista Biology of Reproduction, condus de o echipă multidisciplinară de cercetători din Japonia, atrage atenția asupra unui factor neașteptat de toxicitate în fertilizarea in vitro (FIV): zincul eliberat din sticla utilizată în manipularea și cultivarea embrionilor. Această descoperire poate explica scăderea inexplicabilă a ratelor de succes în procedurile FIV și ar putea duce la metode mai sigure și mai eficiente în medicina reproductivă umană și veterinară.
Context
Tehnologia de reproducere asistată (ART), utilizată în tratamentul infertilității, zootehnie și cercetarea de bază, implică manipularea ovocitelor și a embrionilor în medii de cultură ex vivo. Deși progresele tehnologice din ultimii 50 de ani au crescut semnificativ ratele de naștere prin FIV – de la 5% în anii 1980 la aproximativ 30% astăzi – mediul de cultură al embrionilor rămâne un factor critic care poate influența reușita tratamentului.
În mod obișnuit, procedurile FIV utilizează echipamente din sticlă: plăci cu fund de sticlă pentru observație microscopică, fibre de sticlă în filtre, pipete fine din sticlă pentru injectarea spermatozoizilor (ICSI) și recipiente pentru mediul de cultură.
În cadrul cercetărilor anterioare, echipa a dezvoltat o tehnică de imagerie celulară live, care permite observarea continuă și detaliată a dezvoltării embrionare. Observând variații inexplicabile în rata de dezvoltare a embrionilor, cercetătorii au emis ipoteza că unele echipamente de sticlă pot elibera substanțe toxice.
Despre studiul actual
Echipa de cercetare, coordonată de Kazuo Yamagata de la Universitatea Kindai, împreună cu specialiști de la mai multe universități și instituții de cercetare, a investigat efectele sticlei asupra dezvoltării embrionare la șoareci, bovine și oameni.
Rezultatele principale:
-
Zincul eliberat de sticlă a fost identificat ca principalul agent toxic care inhibă dezvoltarea embrionilor.
-
La șoareci, expunerea la zinc a cauzat:
-
întârzierea dezvoltării embrionare,
-
anomalii în segregarea cromozomială și citokineză,
-
activare anormală a genomului zigotic,
-
scăderea semnificativă a formării blastociștilor.
-
-
După implantare, embrionii expuși la zinc au prezentat rata de naștere comparabilă cu martorii, dar o creștere medie a greutății la naștere cu 18%.
-
Efectele toxice au fost confirmate și în cazul embrionilor umani și bovini, cu variații interspecii privind severitatea efectelor.
Soluții identificate
Pentru a contracara efectele toxice ale zincului, cercetătorii au testat mai multe abordări, cu rezultate pozitive:
-
Adăugarea agentului chelator EDTA (acid etilendiaminotetraacetic) în mediul de cultură, în concentrații și la momente optime, a prevenit efectele toxice.
-
Curățarea riguroasă a echipamentelor din sticlă înainte de utilizare a eliminat riscul de contaminare.
Implicații
Studiul evidențiază un risc major și insuficient recunoscut în reproducerea asistată: toxicitatea ascunsă a materialelor de laborator. Zincul, deși esențial ca oligoelement în organism, devine dăunător atunci când este elibetat necontrolat din echipamentele de laborator, afectând procesele moleculare fundamentale din dezvoltarea embrionară.
„Această cercetare oferă o explicație plauzibilă pentru scăderea inexplicabilă a ratelor de succes în FIV și deschide calea către proceduri mai sigure prin controlul strict al materialelor utilizate.”
— Tatsuma Yao, cercetător principal, Fuso Pharmaceutical Industries
Concluzii
Rezultatele acestui studiu oferă două direcții majore de progres:
-
Modelele animale utilizate (șoareci și bovine) sunt utile în înțelegerea toxicității materialelor în FIV umană.
-
Identificarea zincului drept factor toxic permite adoptarea de măsuri concrete pentru îmbunătățirea siguranței procedurilor FIV.
Aceste constatări reprezintă un pas important în optimizarea mediului de cultură embrionar și pot contribui la creșterea ratelor de succes în reproducerea asistată, atât în scop medical, cât și agricol.
Zinc eluted from glassware is a risk factor for embryo development in human and animal assisted reproduction.
Biology of Reproduction.
doi.org/10.1093/biolre/ioaf050
Image by wayhomestudio on Freepik
Copyright ROmedic: Articolul se află sub protecția drepturilor de autor. Reproducerea, chiar și parțială, este interzisă!
- Detectarea și diagnosticul bolilor folosind o singură moleculă
- Boala von Willebrand în România: între subdiagnosticare și speranță – lansarea platformei vWDtest.com în sprijinul pacienților și al comunității medicale
- Primul transplant de penis realizat cu succes
- Interacțiunea microbiomului intestinal prin transplant
- Fertilizare in vitro
- Calciu, magneziu si zinc ingrasa?
- Inseminare in vitro in clinica din Viena (AKH)
- Sarcina prin fiv - imi trebuie urgent pana miercuri estrofam 2 mg
- Am ambele trompe impermeabile. dupa 2 tratamente Fiv pot ramane insarcinata pe cale naturala?
- Interpretare valori zinc și potasiu serice
- Fertilizare in vitro